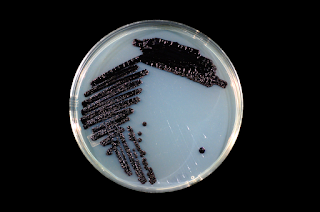

Cuando en 2019 una pareja de amigos me regaló este libro de
Ed Yong, Yo contengo multitudes, ninguno imaginábamos lo que estaríamos
hablando de microbiología a estas alturas. Las multitudes a las que alude Yong
en su título (publicado en 2016) no son las de Walt Whitman, al que homenajea
el verso extraído de Song
to Myself: I am large, I contain multitudes, sino los microbios
que nos habitan, y tal y como Yong nos va a explicar, nos curan, nos permiten
vivir, y hasta nos identifican.
Yo contengo multitudes es una historia de la relación
entre la Humanidad y los microbios basada en el conocimiento que poco a poco
hemos alcanzado sobre nuestro microbioma.
Es un campo científico en que sus especialistas reconocen que queda un campo
amplio por conocer; es por ello apasionante, pero también es interesante por
las posibilidades médicas que abre, y, algo que Yong menciona y explica pero no
profundiza, filosóficas en cuanto ontología, definición de la identidad y del
ser. El subtítulo recoge esta frase, una vez visto el título poético: Los
microbios que nos habitan y una visión más amplia de la vida.
Colonia de Clostridium difficile (foto de CDC/Dr.
Holdeman – Centers for Disease Control and Prevention‘s Public Health Image Library, número #3647). Afecta sobre todo
a personas que han tomado antibióticos.
En su estudio Yong empieza por definir el tiempo que los
microbios, especialmente las bacterias, llevan en la Tierra. Habla también de
cómo dominaron el mundo (dudando que hayan dejado de hacerlo) y cómo influyeron
en la creación de organismos pluricelulares y en la aparición de los animales.
De cómo empezamos a ser conscientes de su existencia (son preciosos los pasajes
dedicados al fabricante de los primeros microscopios, Anton von
Leeuwenhoek), a cómo pasamos a combatirlos cuando supimos que entre ellos
estaban los patógenos fuentes de varias enfermedades, y cómo finalmente somos
conscientes de su importancia en nuestra salud, cómo hemos descubierto
muchísimas más variedades gracias al análisis genético, y cómo intentamos
avanzar en su conocimiento para mejorar nuestra salud.
Yong describe varios descubrimientos verdaderamente
excitantes; entre ellos me impresiona especialmente la transferencia
genética horizontal (TGH), practicada durante millones de años por las
bacterias, y que asegura su pervivencia y selección natural, pero que tiene
investigadores que defienden que sucede también entre animales (humanos
incluidos): parte de nuestro genoma está constituido por genes de las bacterias
que nos habitan, aunque, cuenta Yong, suelan eliminarse esos fragmentos de los resultados
de los análisis genéticos, negando un tanto una intromisión inquietante en
nuestra individualidad (e identidad, incluso) que supera el más confortable
concepto tradicional de simbiosis. Pero tampoco está mal el trasplante
de microbiota fetal (TMF) como técnica utilizada recientemente para
repoblar el microbioma intestinal de pacientes con afecciones graves a través
de la toma de excrementos de personas sanas (los animales suelen comer los
excrementos de sus congéneres, y así mejoran sus propios microbiomas). Por
terminar con un tercer caso impactante, es muy atractiva la explicación de la relación
entre el correcto desarrollo del microbioma de un niño y su modo de nacimiento
(por cesárea el niño no adquiere los microbios de la vagina de su madre), su
lactancia (la natural fomenta el crecimiento de cepas que responden
específicamente a los nutrientes), y su alimentación, factores que parecen clave
en el desarrollo y desempeño del microbioma del individuo.
Janthinobacterium lividum (fotografía de Ninjatacoshell),
bacteria protectora de las ranas y salamandras de Norteamérica
Yong insiste mucho en una idea que le he leído a él y a
otros microbiólogos durante la pandemia del Covid-19, sobre la equivocación de
considerar a los microbios como enemigos contra los que luchar en una guerra
en la que conseguir vencerlos. Más allá de nuestra necesidad de los
microbios para subsistir, y del hecho de que las especies únicamente patógenas
sean un número escaso del total, la visión es equivocada y responde a un
momento científico determinado ya superado. Lo cierto es que el microbioma es
complejo (y variable: cada uno podemos tener cepas diferentes y en cantidades
distintas, y varía entre nuestras diferentes partes del cuerpo) y que, según
las condiciones, la misma bacteria que nos es beneficiosa puede perjudicarnos.
No es que debamos cuidarlas, es que también condicionan cómo debemos
alimentarnos para mantenernos sanos. Su comportamiento, por tanto, se desvía de
conceptos éticos fáciles que no les atañen. Y también pone el autor una pata de
su libro en el mundo natural y la influencia de las bacterias en el desarrollo
o decadencia de especies terrestres y marinas.
Con todo este material, Yong entrega un libro muy ameno,
cercano, de fácil lectura, de clarísimo efecto divulgativo, que combina
historia y biología con habilidad, que se mueve entre ejemplos de especies,
geográficos e individuales otorgando agilidad al texto, sin obviar un humor
blanco y al que es difícil reprochar nada.
No obstante, durante varios pasajes tuve la sensación de que me perdía
mucho conocimiento del que atesora Yong precisamente por la estrategia
divulgativa, como si me atacara una nostalgia por los libros académicos,
clasificatorios, de mayores definiciones, que tuve que estudiar durante mi
formación científica. El libro contiene una bibliografía abundante, una buena
cantidad de notas, y un índice temático que me ha ayudado a repasar el TMF y el
TGH antes de escribir. Y en su estructura y devenir adivino no una pizca de ese
interés subyacente sino su extensa formación científica en Yong: historia de
microbiología, estado del arte actual, técnicas y métodos, potencial futuro.
Son cuatro apartados que tienen capítulos más o menos definidos, aunque en
todos añada las capas de escritura mencionadas. En fin, puede que en realidad
sólo se me haya activado alguna recóndita bacteria que buscaba un alimento
distinto que por ahora no ha encontrado. A Yong, un tipo aparentemente muy
interesante, al menos he empezado a seguirle.
su propia web, tomada por Urszula
Soltys